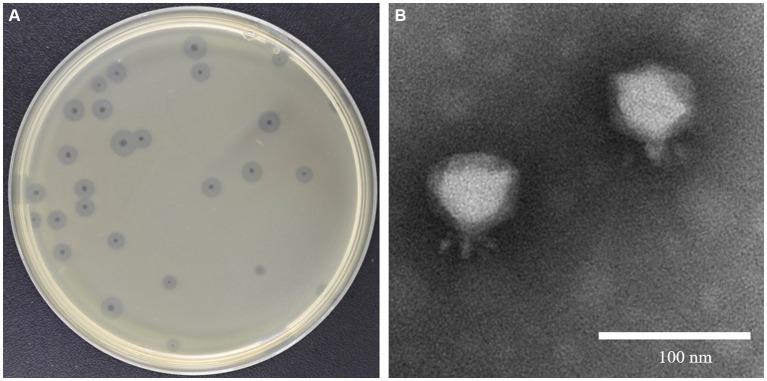

噬菌体工程化内溶素是一种针对“ESKAPEE”病原体的强效广谱杀菌剂。
Engineered endolysin of phage is a potent and broad-spectrum bactericidal agent against "ESKAPEE" pathogens.
作者信息
Chen Wei, Han Li-Mei, Chen Xiu-Zhen, Yi Peng-Cheng, Li Hui, Ren Yun-Yao, Gao Jing-Han, Zhang Cai-Yun, Huang Jing, Wang Wei-Xiao, Hu Zhi-Liang, Hu Chun-Mei
机构信息
Department of Tuberculosis, The Second Hospital of Nanjing, Affiliated to Nanjing University of Chinese Medicine, Nanjing, China.
Clinical Research Center, The Second Hospital of Nanjing, Affiliated to Nanjing University of Chinese Medicine, Nanjing, China.
出版信息
Front Microbiol. 2024 May 9;15:1397830. doi: 10.3389/fmicb.2024.1397830. eCollection 2024.
The rise of antimicrobial resistance in ESKAPEE pathogens poses significant clinical challenges, especially in polymicrobial infections. Bacteriophage-derived endolysins offer promise in combating this crisis, but face practical hurdles. Our study focuses on engineering endolysins from a phage, fusing them with ApoE23 and COG133 peptides. We assessed the resulting chimeric proteins' bactericidal activity against ESKAPEE pathogens . ApoE23-Kp84B (CHU-1) reduced over 3 log units of CFU for , , within 1 h, while COG133-Kp84B (CHU-2) showed significant efficacy against . COG133-L1-Kp84B, with a GS linker insertion in CHU-2, exhibited outstanding bactericidal activity against and . Scanning electron microscopy revealed alterations in bacterial morphology after treatment with engineered endolysins. Notably, CHU-1 demonstrated promising anti-biofilm and anti-persister cell activity against and but had limited efficacy in a bacteremia mouse model of their coinfection. Our findings advance the field of endolysin engineering, facilitating the customization of these proteins to target specific bacterial pathogens. This approach holds promise for the development of personalized therapies tailored to combat ESKAPEE infections effectively.
ESKAPEE病原体中抗菌药物耐药性的上升带来了重大的临床挑战,尤其是在混合感染中。噬菌体来源的内溶素有望应对这一危机,但面临实际障碍。我们的研究重点是对一种噬菌体的内溶素进行工程改造,将它们与ApoE23和COG133肽融合。我们评估了所得嵌合蛋白对ESKAPEE病原体的杀菌活性。ApoE23-Kp84B(CHU-1)在1小时内使肺炎克雷伯菌、金黄色葡萄球菌和粪肠球菌的CFU减少超过3个对数单位,而COG133-Kp84B(CHU-2)对大肠杆菌显示出显著疗效。在CHU-2中插入GS接头的COG133-L1-Kp84B对肺炎克雷伯菌和金黄色葡萄球菌表现出出色的杀菌活性。扫描电子显微镜显示,经工程改造的内溶素处理后细菌形态发生改变。值得注意的是,CHU-1对肺炎克雷伯菌和金黄色葡萄球菌表现出有前景的抗生物膜和抗持留菌活性,但在它们共感染的菌血症小鼠模型中疗效有限。我们的研究结果推动了内溶素工程领域的发展,有助于定制这些蛋白质以靶向特定的细菌病原体。这种方法有望开发出个性化疗法,有效地对抗ESKAPEE感染。